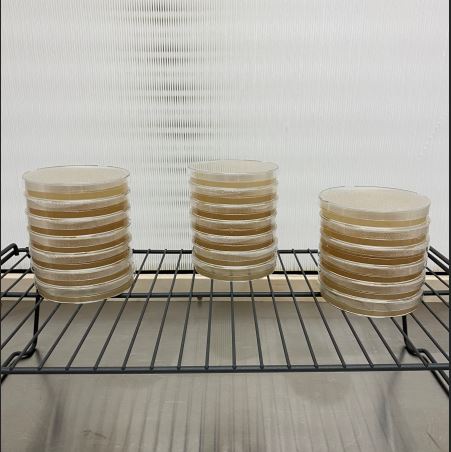
Pre-poured Agar Plates | 90mm LME Agar Plates

Collection: Sterile Agar Plates for Mushroom Cultivation
Ideal for Isolating and Expanding Mycelium
Our agar plates are poured under sterile lab conditions, making them perfect for isolating, cloning, or expanding mushroom cultures
Find pre-poured sterile agar plates that you can grow out your favourite mushroom cultures on and preserve genetics! Or if you prefer to make your own agar from scratch we offer full sleeves of sterilized petri dishes for all your needs.
Agar plates are a great way to grow out mushroom spores, tissue clones and testing liquid culture viability
-
Pre-poured Agar Plates | 90mm LME Agar Plates
Regular price From $35.00Regular priceUnit price / per$28.00Sale price From $35.00 -
Sleeve of Sterile Petri Dishes (25 pack) | 90mm Petri Dishes
Regular price $20.00Regular priceUnit price / perSale price $20.00